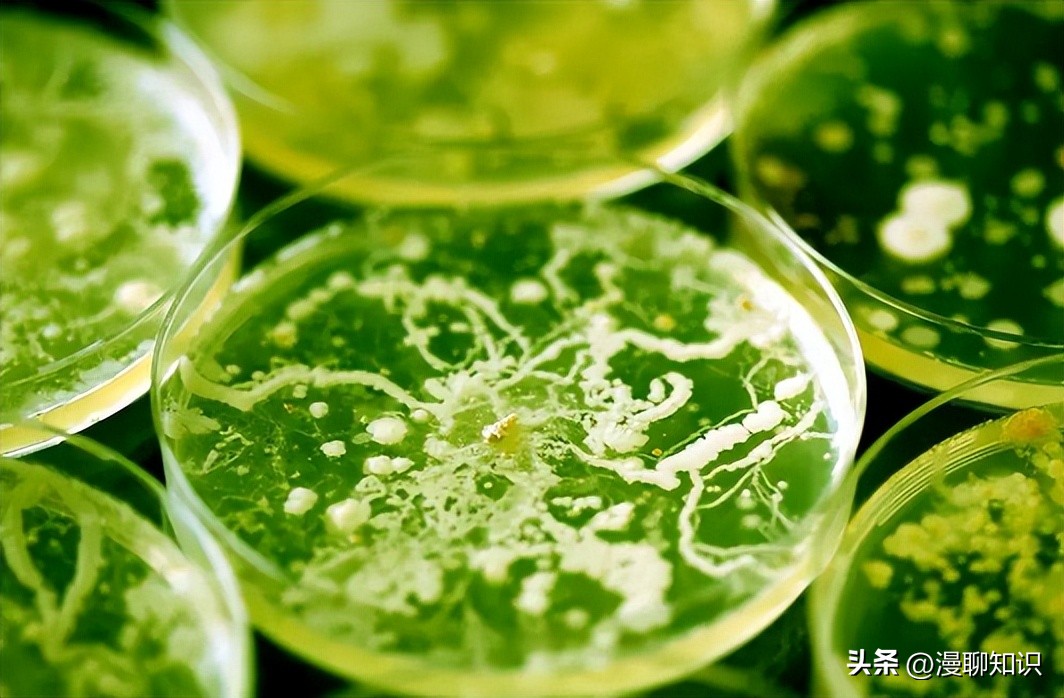
呕吐毒素超标对人体有什么危害,呕吐毒素多少剂量对身体造成危害

阅读文章前,辛苦您点下右上角的“关注”,方便您讨论分享,持续关注每日优质内容~
呕吐毒素,又名脱氧雪腐镰刀菌烯醇(deoxynivalenol,DON),是一种由镰刀菌属产生的有毒的次级代谢产物。
在谷物及其加工副产品中经常检测到DON污染。
DON能够在食物链中积累,当家畜摄入了被DON污染的食物后会产生厌食、呕吐、腹泻、发烧等急性中毒症状,严重时损害造血系统造成死亡。
DON被国际癌症研究机构归类为第3类致癌物质,可引起急性毒性、胃肠道毒性、肝毒性、免疫毒性、发育毒性、生殖毒性、神经毒性、核糖体毒性等。

近几年,DON污染非常严重,DON污染防控是世界性难题,在非洲、亚洲、美洲、欧洲和中东等均很普遍。
2004年至2011年对全球17 316个样本的调查显示,与玉米赤霉烯酮(ZEN)、黄曲霉毒素(AFT)、伏马菌素(FB)和赭曲霉毒素A(OTA)相比,DON是最主要的毒素污染,污染率为55%。
2018年进行的另一项调查,其中包括来自全球77个国家的13 629个样本,表明DON是分布广泛的毒素之一。
DON因其污染普遍和对人畜健康的危害,迫切需要开发有效降解DON的方法。

目前针对DON污染防控已有许多报道,包括DON的田间管理和培育抗病作物等,以及使用物理、化学和生物方法对毒素进行脱毒。
物理和化学方法包括臭氧处理、紫外照射、过热蒸汽和碱处理等。
然而,由于DON的结构性质稳定,传统的物理方法的效率很低;化学方法虽然可以达到很好的解毒效果,但与其他有毒化学物质混合破坏了饲料的营养品质和价值。
另外,物理和化学方法设施设备条件要求高。

生物降解因其具有高效、反应条件温和、可持续性和环境友好等优点,具有开发应用前景,受到越来越多研究人员的关注。
目前,在国内外已经有大量有关微生物降解DON的报道。
Zhang等从海水中筛选到1株耐盐海杆菌(Pelagibacterium halotolerans)ANSP101,在12 h内将DON(50 μg/mL)降解了76.85%,其发挥作用的是细胞裂解液中的胞内酶。
Shima等从土壤中富集到了1株根瘤农杆菌(Agrobacterium rhizobium)E3-39,可以在24 h内完全降解DON(200 μg/mL)。

Jia等从驴肠道中分离到1株枯草芽孢杆菌(Bacillus subtilis)ASAG 216,能在8 h内对100 μg/mL DON降解81.1%,其活性物质来自培养上清液中的胞外酶。
本研究从霉菌毒素污染严重的田地和养殖场中采集了土壤和动物(鸡、猪)粪便等样品,以DON为唯一碳源,筛选能够降解DON的微生物,初步研究土壤及猪、鸡粪便中是否存在能有效降DON的微生物、该菌株解毒活性物质的分布、DON降解产物对猪小肠上皮细胞(IPEC-J2)的毒性作用,从而为食品和饲料中DON污染防控提供一种选择。

样品采自黄淮海区域小麦田和玉米田土壤以及鸡、猪养殖场粪便。
材料:DON购自青岛某生物工程有限公司,溶于*腈乙**(纯度99.9%),终浓度为10 μg/mL。
营养肉汤培养基(NB)、营养琼脂培养基(NA)、DMEM培养基、胎牛血清(FBS)、青霉素-链霉素、磷酸盐缓冲液(PBS)、胰蛋白酶和二甲基*砜亚**(DMSO)、蛋白酶K(PK)、十二烷基硫酸钠(SDS)均购自北京索莱宝科技有限公司;细菌基因组DNA纯化试剂盒购自北京天根生化科技有限公司;Annexin V-EGFP/PI Apoptosis Detection Kit购自江苏凯基生物技术股份有限公司;Cell Counting Kit-8购自大连美仑生物技术有限公司;IPEC-J2细胞由河南农业大学动物医学院杨旭博士赠予。

培养基配制:富集培养基,0.25 g NaNO3,0.25 g KCl,1 g K2HPO4,0.1 g Fe2(SO4)3·7H2O,0.5 g MgCl2,0.1 g酵母膏,0.1 g玉米浆,调pH至7.0,用蒸馏水定容至1 L,121 ℃灭菌30 min。
初筛培养基,0.5 g (NH4)2SO4,0.2 g MgSO4·7H2O,0.05 g CaCl2,2.44 g NaH2PO4,1.52 g KH2PO4,琼脂15 g,调pH至7.0~7.2,用蒸馏水定容至1 L,121 ℃灭菌30 min,以DON(1 μg/mL)为唯一碳源。
IPEC-J2细胞在含有4.5 g/L葡萄糖、10%胎牛血清、青霉素(100 IU/mL)和链霉素(100 mg/mL)的DMEM培养基中,在37 ℃、5%二氧化碳(CO2)的培养箱中培养。

从粪便和土壤*共中**采集了60份样品,每份样品取1 g溶于10 mL生理盐水中,室温下160 r/min振荡1 h,静置10 min。
吸取1 mL上清至2 mL离心管中,4 000 r/min离心2 min。
吸取1 mL上清液添加至富集培养基中培养24 h。
将富集后的菌液梯度稀释,涂布于初筛培养基上培养72~96 h。
挑选初筛培养基中长势优良的菌落,接种于富集培养基中,37 ℃培养24 h;培养结束后吸取100 μL菌液涂布至初筛培养基中继续培养72~96 h,重复3次。
将长势良好的单菌落进行纯化培养,用50%的甘油保存,置于-80 ℃冰箱中保存备用。
将上述试验筛选得到的菌株活化扩增,然后与DON(终浓度1 μg/mL)共同孵育96 h,待结束后加入等体积的甲醇并涡旋10 s来终止反应。
在4 ℃、12 000 r/min离心3 min,上清液先通过0.22 μm滤器过滤,再通过DON免疫亲和柱纯化,然后应用高效液相色谱仪(Agilent-1290)进行分析[24,27]。
液相色谱条件:色谱柱为Eclipse Plus C18(2.1 μm×100 mm,1.8 μm),进样量为2 μL,流动相为*腈乙**-水(10∶90),流速为0.1 mL/min,柱温为30 ℃,检测波长为218 nm。

参照《伯杰氏细菌鉴定手册(第8版)》的研究方法,对菌株进行形态学和生理生化鉴定。
应用16S rRNA和特异性序列gyrB测序对分离筛选到的菌株进行鉴定。
提取菌株基因组DNA,设计16S rRNA序列和gyrB基因的引物,PCR扩增产物送尚亚生物技术有限公司进行测序。
应用MEGA11.0版软件包,采用邻接法构建系统发育树,构建1 000个Bootstrap重复序列。
|
引物名称 Primer name |
引物功能 Primer function |
序列 Sequence |
|
27F |
16S rRNA测序 |
5′-AGAGTTGATCCTGGCTCAG-3′ |
|
1492R |
16S rRNA测序 |
5′-GGTTACCTTGTTACGACTT-3′ |
|
UP-1 |
gyrB扩增 |
5′-GAAGTCATCATGACCGTTCTGCA(TC)GC(TCAG)GG(TCAG) GG(TCAG)AA(AG)TT(TC)GA-3′ |
|
UP-2r |
gyrB扩增 |
5′-AGCAGGGTACGGATGTGCGAGCC(AG)TC(TCAG)AC(AG) TC(TCAG)GC(AG)TC(TCAG)GTCAT-3′ |
|
UP-1S |
gyrB测序 |
5′-GAAGTCATCATGACCGTTCTGCA-3′ |
|
UP-2sr |
gyrB测序 |
5′-AGCAGGGTACGGATGTGCGAGCC-3′ |

参考Rao等的方法,测定筛选细菌培养液、细胞悬浮液、培养上清液和细胞裂解液等组分对DON的降解能力。
将筛选菌接种于NB培养基中,37 ℃培养24 h制得培养液。
细胞悬浮液制备:细菌培养液离心后去除上清液,细菌沉淀经PBS洗涤3次并重新悬浮。
培养上清液制备:细菌培养液离心得到上清液,0.22 μm滤器过滤。

细胞裂解液制备:细胞沉淀经PBS悬浮,使用细胞超声波仪粉碎(400 W,工作5 s,间歇5 s),在4 ℃、6 000 r/min条件下离心10 min,取上清液,应用0.22 μm滤器过滤。
将100 μL DON(终浓度1 μg/mL)分别加入900 μL细菌培养液、细胞悬浮液、培养上清液和细胞裂解液中,在37 ℃培养48 h。
以NB培养基和PBS作为空白对照,应用UPLC检测DON的残留量,从而确定活性物质的分布。

为了进一步研究活性物质的性质,应用加热、SDS和PK对主要活性组分进行处理,检测DON的降解率。
各组处理方案如下:加热处理,100 ℃处理培养上清液30 min;SDS处理,加入1% SDS,37 ℃作用6 h;PK处理,加入10 mg/mL的PK,37 ℃水浴1 h;SDS+PK处理,加入10 mg/mL的PK,10% SDS,37 ℃作用6 h。
将不同处理分别与DON(10 μg/mL)在37 ℃,180 r/min孵育72 h。
应用UPLC检测DON的残留量。

DON溶液的配制。
将H7菌株培养液,在4 ℃、10 000 r/min的条件下离心,然后0.22 μm滤膜过滤,收集上清液。
将DON溶于上清液中,分别用含有10% FBS和1%青-链霉素的完全培养基配成浓度分别为0.5和1.0 μg/mL的DON溶液,0.22 μm滤膜过滤。
DON降解产物溶液配制,将H7菌株培养液与DON(1.0 μg/mL)在37 ℃孵育,使DON的浓度达到0.5 μg/mL(UPLC测定)。
在4 ℃、10 000 r/min条件下离心,0.22 μm滤膜过滤,收集到的上清液立即放入4 ℃冰箱保存。
降解产物经过DON免疫亲和柱,去除DON,收集剩余液体。
收集到的液体经过冷冻离心浓缩仪,浓缩之后,再分别用含有10% FBS和1%青-链霉素的完全培养基配成浓度分别为0.5和1.0 μg/mL的降解产物溶液。
NC组:不含DON的上清液配成的细胞完全培养基。
操作全程在4 ℃无菌条件下进行。